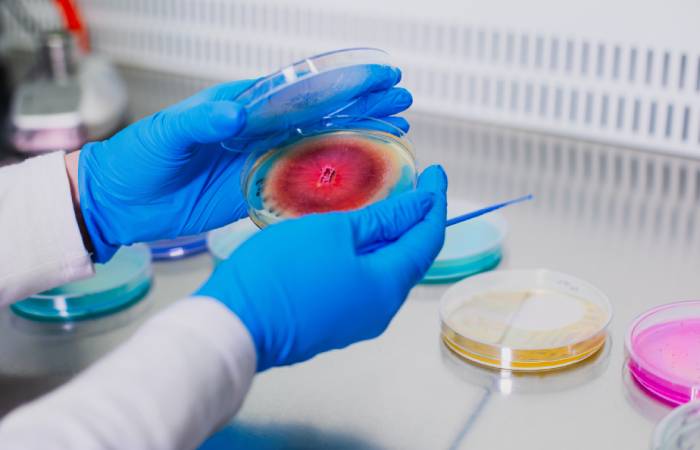

W dobie presji ekologicznej, coraz większą wagę przykłada się do nowych rozwiązań technologicznych w produkcji rolnej, zapewniających rozwój ekosystemów i jednocześnie zapobiegających degradacji środowiska. Stanowi to zarówno wyzwania, jak i duże szanse dla producentów innowacyjnych preparatów z dziedziny „zielonej biotechnologii”, w czym od ponad 10 lat specjalizuje się przedsiębiorstwo Bacto-Tech z Aleksandrowa Kujawskiego. Jaką rolę w poprawie jakości gleby oraz plonów rolnych odgrywają mikroorganizmy? Jak duży udział stanowią technologie oparte na mikrobiologii i gdzie możemy zobaczyć ich zastosowanie?
Mikrobiologia dla zrównoważonego rolnictwa
XX wiek był erą rozwiązań bazujących na chemii, także w uprawach, gdzie dominowały nawozy mineralne i chemiczne środki ochrony roślin. Obecnie, coraz więcej wagi przykłada się do rozwiązań naturalnych. Biologia, w tym mikrobiologia, coraz częściej wspomaga, a nawet zastępuje konwencjonalne rozwiązania. – Biopreparaty mikrobiologiczne są skutecznym narzędziem w optymalizacji produkcji rolniczej poprzez poprawę struktury gleby, zwiększenie dostępności składników odżywczych oraz stymulację wzrostu roślin. Mikrobiologia oferuje też wiele rozwiązań w zakresie biokontroli chorób i szkodników upraw. W ten sposób ich zastosowanie przyczynia się do zwiększenia wydajności upraw, zmniejszenia użycia chemikaliów i promowania zrównoważonej praktyki rolniczej.
Mikroorganizmy są także ważnym elementem wspomagającym w hodowli – suplementacja bakterii probiotycznych wspiera zdrowie zwierząt, a bakteryjne inokulanty poprawiają jakość kiszonek – mówi Aleksandra Burkowska-But, współwłaścicielka Bacto-Tech, firmy, która specjalizuje się w dziedzinie „zielonej biotechnologii” wykorzystywanej w rolnictwie i ochronie środowiska. Przedsiębiorstwo prowadzi badania i wdrożenia dotyczące innowacyjnych nawozowych produktów mikrobiologicznych, które promują wzrost roślin, poprawiają dostępność pierwiastków biogennych i niwelują skutki tzw. stresów środowiskowych, np. suszy, jak i zajmuje się działalnością produkcyjną. Wytwarza także produkty przeznaczone do stosowania w domu, w ogródkach, na trawnikach czy w branży HORECA. Bacto-Tech realizuje również badania w zakresie optymalizacji produkcji mikroorganizmów stanowiących główny składnik aktywny produktów oraz ich lepszej stabilizacji w wyrobie gotowym, co zapewnia trwałość i powtarzalną jakość w całym okresie przydatności do zastosowania.
– Nasza firma powstała jako spin-off z inicjatywy pracowników Uniwersytetu Mikołaja Kopernika w Toruniu. Postanowiliśmy urzeczywistnić w praktyce rynkowej naszą wiedzę i wieloletnie doświadczenia z zakresu mikrobiologii środowiskowej. Od 3 lat jesteśmy już w pełni samodzielną firmą – wspomina Aleksandra Burkowska-But. Bacto-Tech jest dziś producentem 30 produktów znajdujących się w Wykazie nawozowych produktów mikrobiologicznych IUNG-PIB, a także takich, jak bioudrażniacze do szamb czy nawozów pochodzenia zwierzęcego. W ub. roku firma odnotowała rekordowy poziom produkcji (ponad 160 tys. litrów biopreparatów), co czyni ją jednym z czołowych liderów w dziedzinie nawozów mikrobiologicznych.
Dotychczas spółka uczestniczyła jako lider, konsorcjant lub podwykonawca w 6 projektach badawczo-rozwojowych. Kolejny zrealizowała już całkowicie samodzielnie. Dotyczył on pozyskania nowych szczepów bakterii o dużym potencjale aplikacyjnym, przeznaczonych do biologizacji środowiska glebowego. – W efekcie na rynku pojawiły się nasze główne produkty dla rolnictwa przyspieszające rozkład resztek pożniwnych i wspomagające odżywianie roślin fosforem, które znalazły stałe miejsce w praktykach rolniczych. Każdy z realizowanych projektów zaowocował wprowadzeniem na rynek nowych produktów lub rozwiązań technologicznych dających zastosowanie dla mikroorganizmów, nie tylko w rolnictwie, ale też np. w preparatach chemii gospodarczej.
Nowość: BactoStym Nitro
Aktualnie Bacto-Tech silnie angażuje się w umocnienie na rynku swojego nowego produktu BactoStym Nitro. Jest to dolistny preparat mikrobiologiczny poprawiający przyswajanie azotu. Znajduje się on w wykazie nawozowych produktów mikrobiologicznych IUNG – PIB w Puławach, jest również dopuszczony do stosowania w rolnictwie ekologicznym. Jego główny składnik aktywny – bakterie Arthrobacter nicotinovorans kolonizują tkanki liści i udostępniają azot roślinie w miejscu o największym zapotrzebowaniu na ten pierwiastek, przez większość sezonu wegetacyjnego, niezależnie od stosowanego nawożenia mineralnego. BactoStym Nitro stanowi uzupełnienie nawożenia mineralnego i pozwala znacząco je obniżyć (o 20–30 proc.) bez straty w plonie. Ważną cechą BactoStym Nitro jest zastosowanie jako nośnika zagęszczonego płynu pohodowlanego drobnoustrojów. Pełni on podwójną funkcję – stabilizuje komórki drobnoustrojów w trakcie przechowywania i jednocześnie jest bogaty w metabolity mikroorganizmów (hormony, aminokwasy, witaminy) stymulujące wzrost i plonowanie roślin.
Za opracowanie BactoStym Nitro w 2025 r. Bacto-Tech otrzymał tytuł Lidera Innowacji Pomorza i Kujaw w kategorii małych przedsiębiorstw oraz został wyróżniony Nagrodą Prezesa Pomorskiej Specjalnej Strefy Ekonomicznej.
W 2023 r. firma została uhonorowana nagrodą Polonica Progressio jako Lider innowacji. Jest także ubiegłorocznym Laureatem Programu Najwyższa Jakość Quality International i zdobywcą Złotego Godła QI 2025 w kategorii Produkt za serię FabaStym – 6 biopreparatów do zaszczepiania nasion roślin bobowatych. W tym roku walczy o swój drugi medal, tym razem właśnie dla produktu BactoStym Nitro.
Jakość potwierdzona
Bacto-Tech stawia na badania dotyczące opracowywania nowych wyrobów, a także optymalizacji wytwarzania mikroorganizmów stanowiących ich główny składnik aktywny. Opracowuje metody najlepszej stabilizacji biopreparatów, co zapewnia ich trwałość i jednakową jakość w całym okresie przydatności do użycia. – Ostatnie 3 lata były przełomowe. Ze względu na wprowadzanie w życie założeń Europejskiego Zielonego Ładu, ale też z uwagi na wzrost cen nawozów mineralnych (głównie azotowych) po inwazji Rosji na Ukrainę, rynek coraz bardziej zaczął się interesować zastosowaniem biopreparatów mikrobiologicznych w uprawie. Jeszcze kilka lat temu niewiele osób rozumiało ideę zastosowania mikroorganizmów wspomagających wzrost roślin, a jeszcze mniej firm było zainteresowanych wprowadzaniem ich na rynek. Dziś w wykazie nawozowych produktów mikrobiologicznych znajduje się ponad 350 takich pozycji – zaznacza Aleksandra Burkowska-But, i dodaje: – Mimo dużej konkurencji na rynku, jesteśmy pewni, że jakość naszych produktów, a także doświadczenie i własne zaplecze badawcze, to czynniki, które zapewniają nam przewagę. Dlatego nie tylko wdrażamy wewnętrzne systemy zarządzania, ale weryfikujemy też jakość naszych preparatów w akredytowanych laboratoriach zewnętrznych, a ich skuteczność sprawdzamy we współpracy z renomowanymi ośrodkami badawczymi. Większość naszych technologii posiada krajowe i zagraniczne certyfikaty kwalifikujące do stosowania w rolnictwie ekologicznym, a bioudrażniacze posiadają atest higieniczny Narodowego Instytutu Zdrowia Publicznego – Państwowego Zakładu Higieny. Dbałość o jakość, to także nieustanne podwyższanie kwalifikacji naszych pracowników poprzez udział w szkoleniach i konferencjach naukowych – podkreśla właścicielka Bacto-Tech.
Joanna Chrustek

